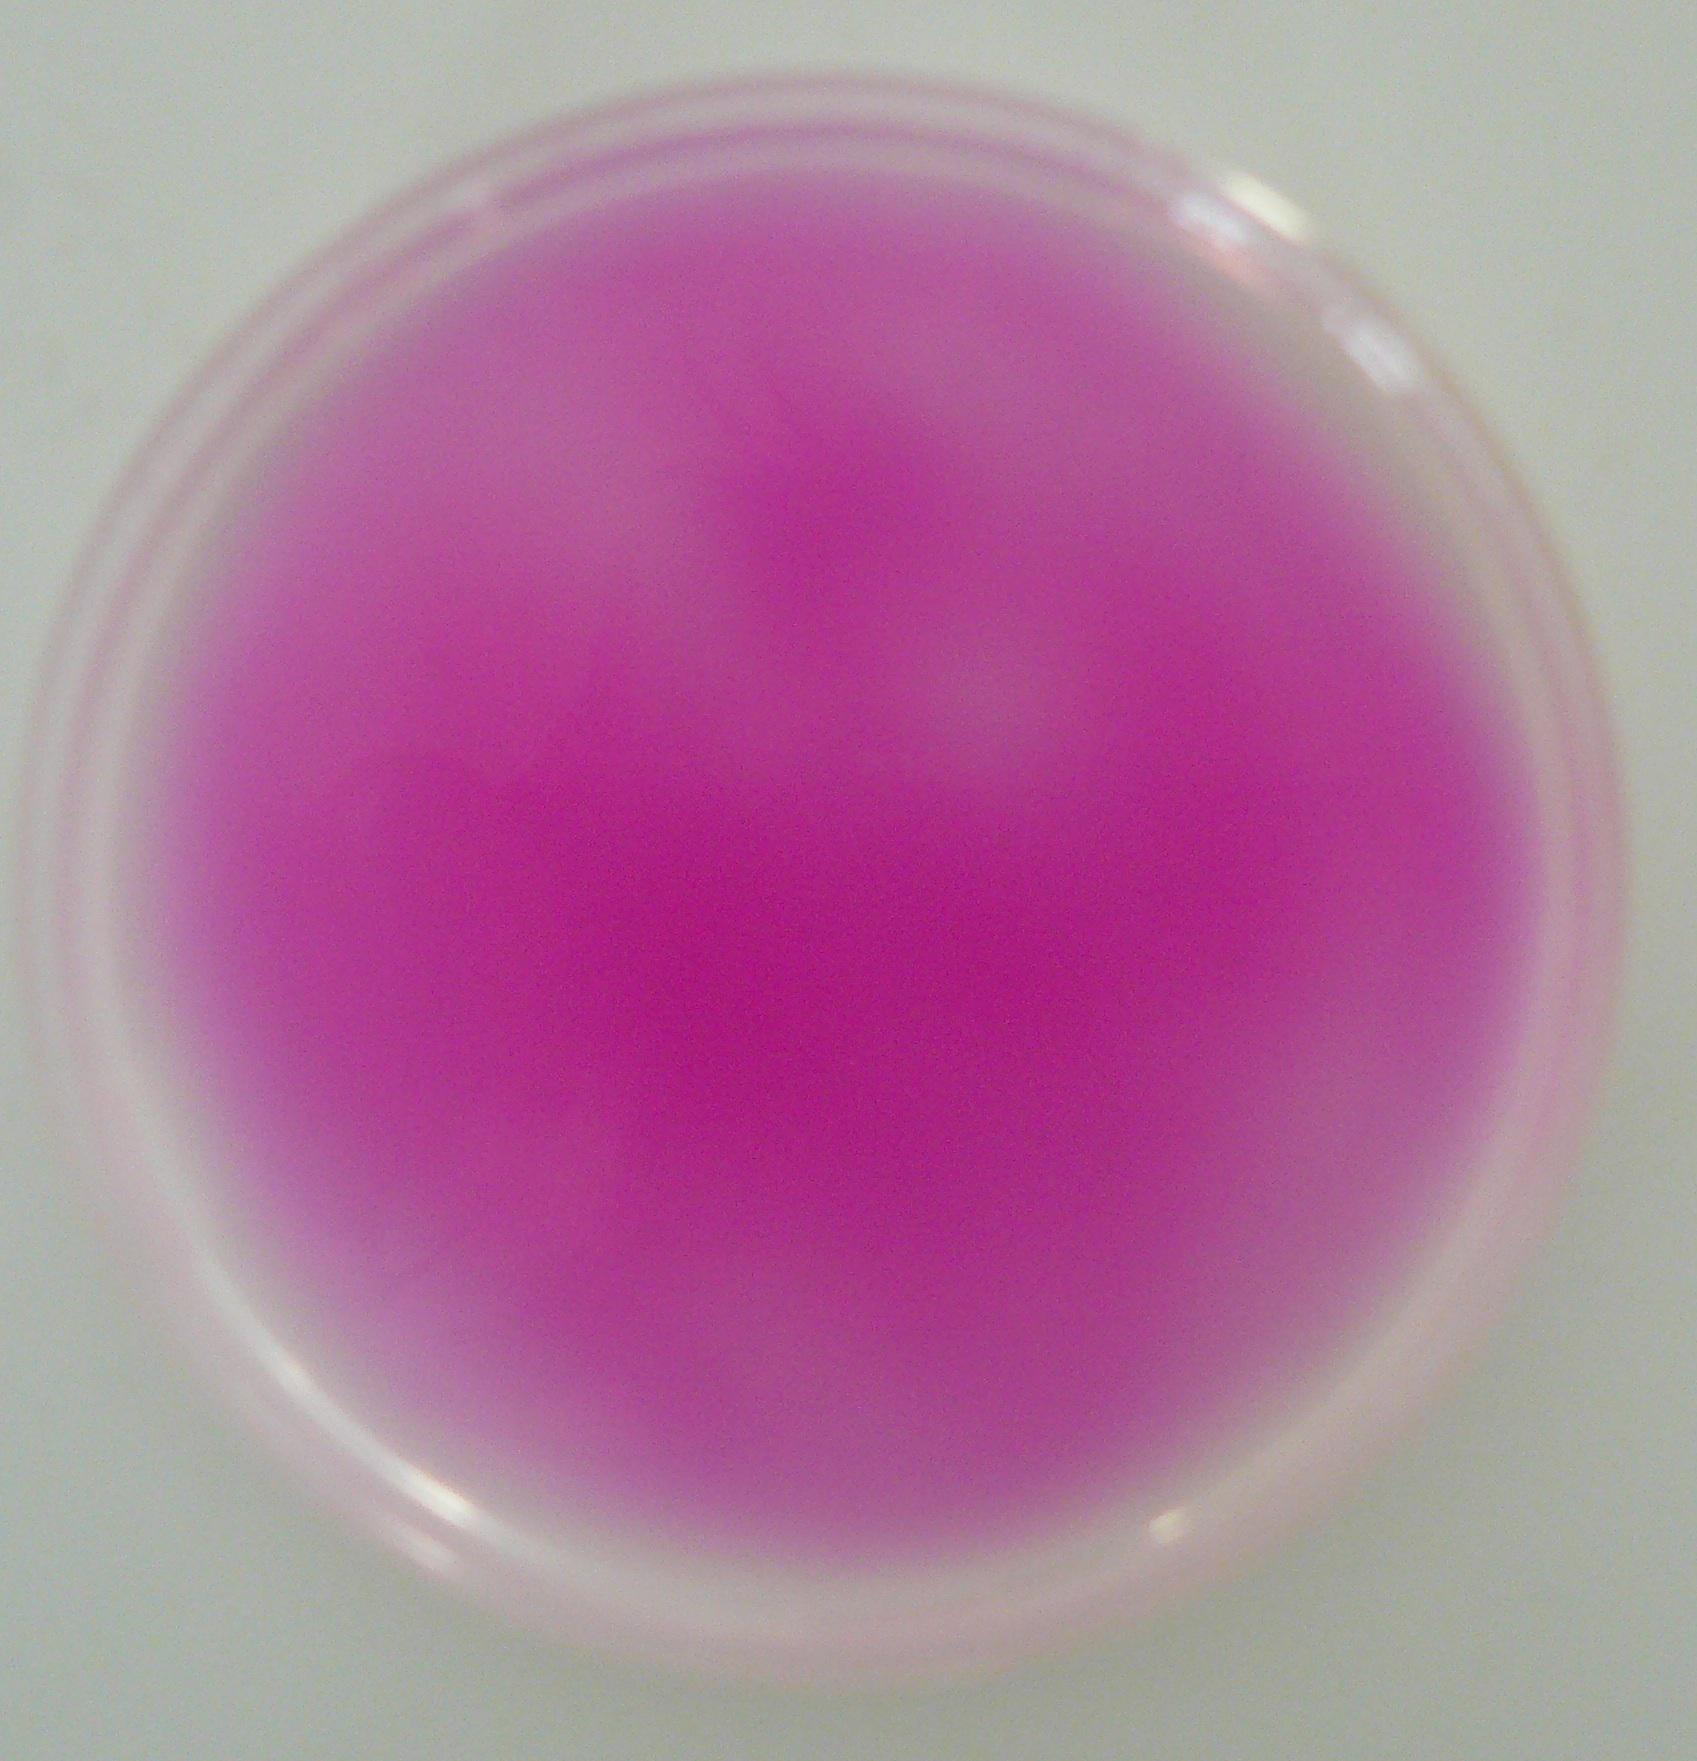
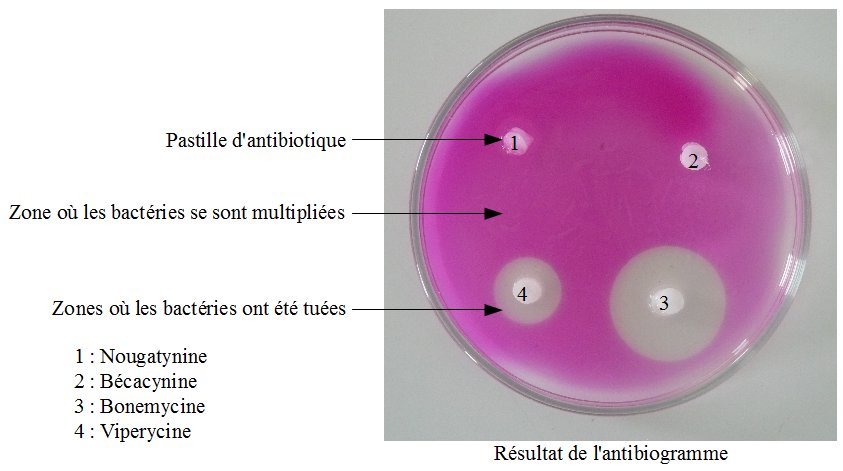

- Cycle 4
- Terminale
- scénario, séquence
- enseignant
- élève
- classe
Choisir le bon antibiotique (Utilisation de produits de substitution)
Les produits utilisés sont des produits de substitution aussi bien pour les antibiotiques que pour les populations bactériennes.

Situation de départ
Monsieur X est malade (fièvre, gorge gonflée, maux de tête). Il se rend donc chez son médecin traitant.
Celui-ci lui diagnostique une infection bactérienne et lui prescrit un antibiotique : la Nougatynine.
Après quinze jours de traitement, Monsieur X ressent toujours les symptômes de la maladie.
Pour comprendre, son médecin décide alors de faire un prélèvement, de mettre en culture les bactéries responsables. Puis de faire un antibiogramme.
Question
Protocole élève
-d'une boîte de Pétri où les bactéries ont été mises en culture
-de quatre tubes à essai contenant un antibiotique différent
-d'une paire de pinces par tube d'antibiotique
-de gants et de lunettes de protection
À l'aide des pinces, imbibez une pastille en la trempant dans un tube d'antibiotique.
Puis disposez la en vous aidant du gabarit (ci-contre).
Fiches d'aide
Critères d'évaluation
- Les résultats sont dessinés et légendés
- Le cas de monsieur X est expliqué et justifié
- Le protocole expérimental est respecté
- Le matériel est rangé en fin d'expérience
- Le travail s'est fait en autonomie (calme et respect des règles de sécurité)
- Les réponses sont rédigées dans un langage clair et adapté
Le principe de l'antibiogramme
Un antibiogramme est une technique de laboratoire visant à tester la sensibilité d'une bactérie vis à vis de plusieurs antibiotiques.
Le principe consiste à placer la culture de bactéries en présence de pastilles imbibées d'antibiotiques.
Interprétation :
Ces bactéries ne sont pas sensibles aux antibiotiques 1 et 3.
Mais elles sont un peu sensibles à l'antibiotique 2 et très sensibles à l'antibiotique 4

La croissance bactérienne
C'est à dire qu'une bactérie va donner deux bactéries en se " coupant " en deux (voir schéma ci-dessous).
Et ceci toutes les 20 à 30 minutes.
Les bactéries sont cultivées dans des boîtes de Pétri sur un gel où elles trouvent tout ce qu'elles ont besoin pour se reproduire (eau, sucre).
Voir photographie ci-dessous.

Réponses attendues
D'après mon antibiogramme, la Nougatynine et la Bécacynine ne tuent pas les bactéries responsables de la maladie de monsieur X.
Ce qui explique pourquoi monsieur X est toujours malade après 15 jours de traitement.
La Bonemycine et la Viperycine tuent les bactéries responsables de la maladie de monsieur X.
La Viperycine est plus efficace (zone d'inhibition de la croissance des bactéries plus grande), c'est donc cet antibiotique que je propose pour soigner le patient.
Information(s) pédagogique(s)
Ressources associées
-

préparation d'un antibiogramme de substitution
- 1ère S
- Terminale S
- Cycle 4
- travaux pratiques
- enseignant
- personnel de laboratoire
- laboratoire
-
-

Amélioration de l'antibiogramme avec produits de substitution
- 3ème
- 1ère S
- travaux pratiques
- personnel de laboratoire
- enseignant
- laboratoire
- classe


